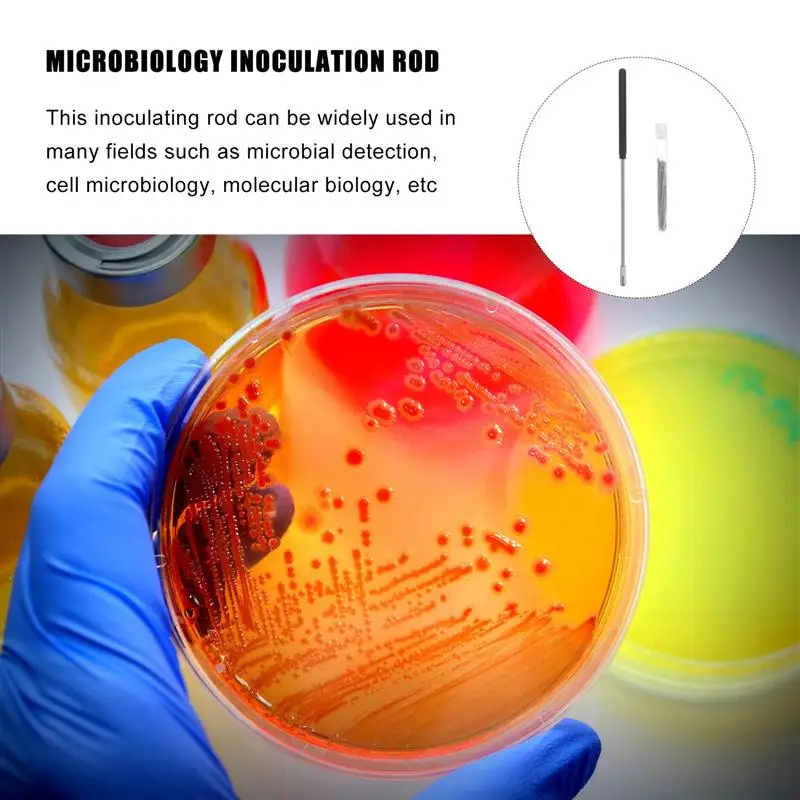

1 Набор, лабораторный инструмент для биологического эксперимента 




506,42₽
В наличии!
Tech FUN Store - Надежность 95%
Более 24 подписчиков, дата открытия магазина 10.04.2021
- Положительные оценки: 96% (98)
- Соответствие описанию: 96%
- Отвечает на сообщения: 94%
- Скорость отправки: 94%
Последнее обновление: 17.04.2022
Латунные стержни, 10 шт., 1,6x250 мм, золотые стержни для ремонта, ...
155,89₽
Последнее обновление: 16.09.2024
Механический карандаш Deli 0,50,7 мм со свинцовыми стержнями 2B HB,...
269,82₽
Последнее обновление: 13.09.2024
1 Набор экспериментный инструмент для инъекции, аксессуар для культ...
348,61₽
Последнее обновление: 27.09.2024
Инструмент для вытягивания сцепления первичного привода для тележки...
1 860,60₽
Последнее обновление: 10.03.2022
Металлическая шариковая ручка со стразами и разбитыми стразами
66,54₽
Последнее обновление: 16.04.2022
Описание
Вы ищете профессиональный, но доступный биологический эксперимент прививки стержень? Вы ищете прочный и надежный инструмент, который может сделать несколько рабочих мест сразу? Если да, не смотрите дальше! Наш профессиональный биологический эксперимент прививки стержень должен удовлетворить ваши потребности. Это один из лучших вариантов для вас.
Особенности
-Цвет: черный и серебристый.
-Материал: нержавеющая сталь, никель-Хромовая проволока, пластик.
-Размер: 22.00X0.50X0.50 см/8.65X0.20X0.20 дюймов.
-Прививочная Петля-это широко используемый инструмент для культура бактерий.
-Прививочная палочка может завершить нарезание и резка, чтобы завершить весь процесс прививки.
-Этот прививочный стержень может широко использоваться во многих областях, таких как микробное обнаружение, клеточная микробиология, молекулярная биология и т. д.
-Применяется для химического тестирования, научных экспериментов, школьного обучения и т. д.
-Прививочный стержень может быть использован для прививания агарного сланца в съедобной грибковой среде.
Упаковочный лист
1 x стержень для прививки 100 x провода для прививки












Вопросы еще не задавались...
-
Вес логистики0.035
-
Каждая упаковка1
-
Минимальная единица измерения100000015
-
Название брендаNUOLUX
-
Номер моделиLaboratory Tool
-
Продано Вsell_by_piece
-
ПроисхождениеКитай
-
Размер логистики - высота (см)1
-
Размер логистики - длина (см)23
-
Размер логистики - ширина (см)1